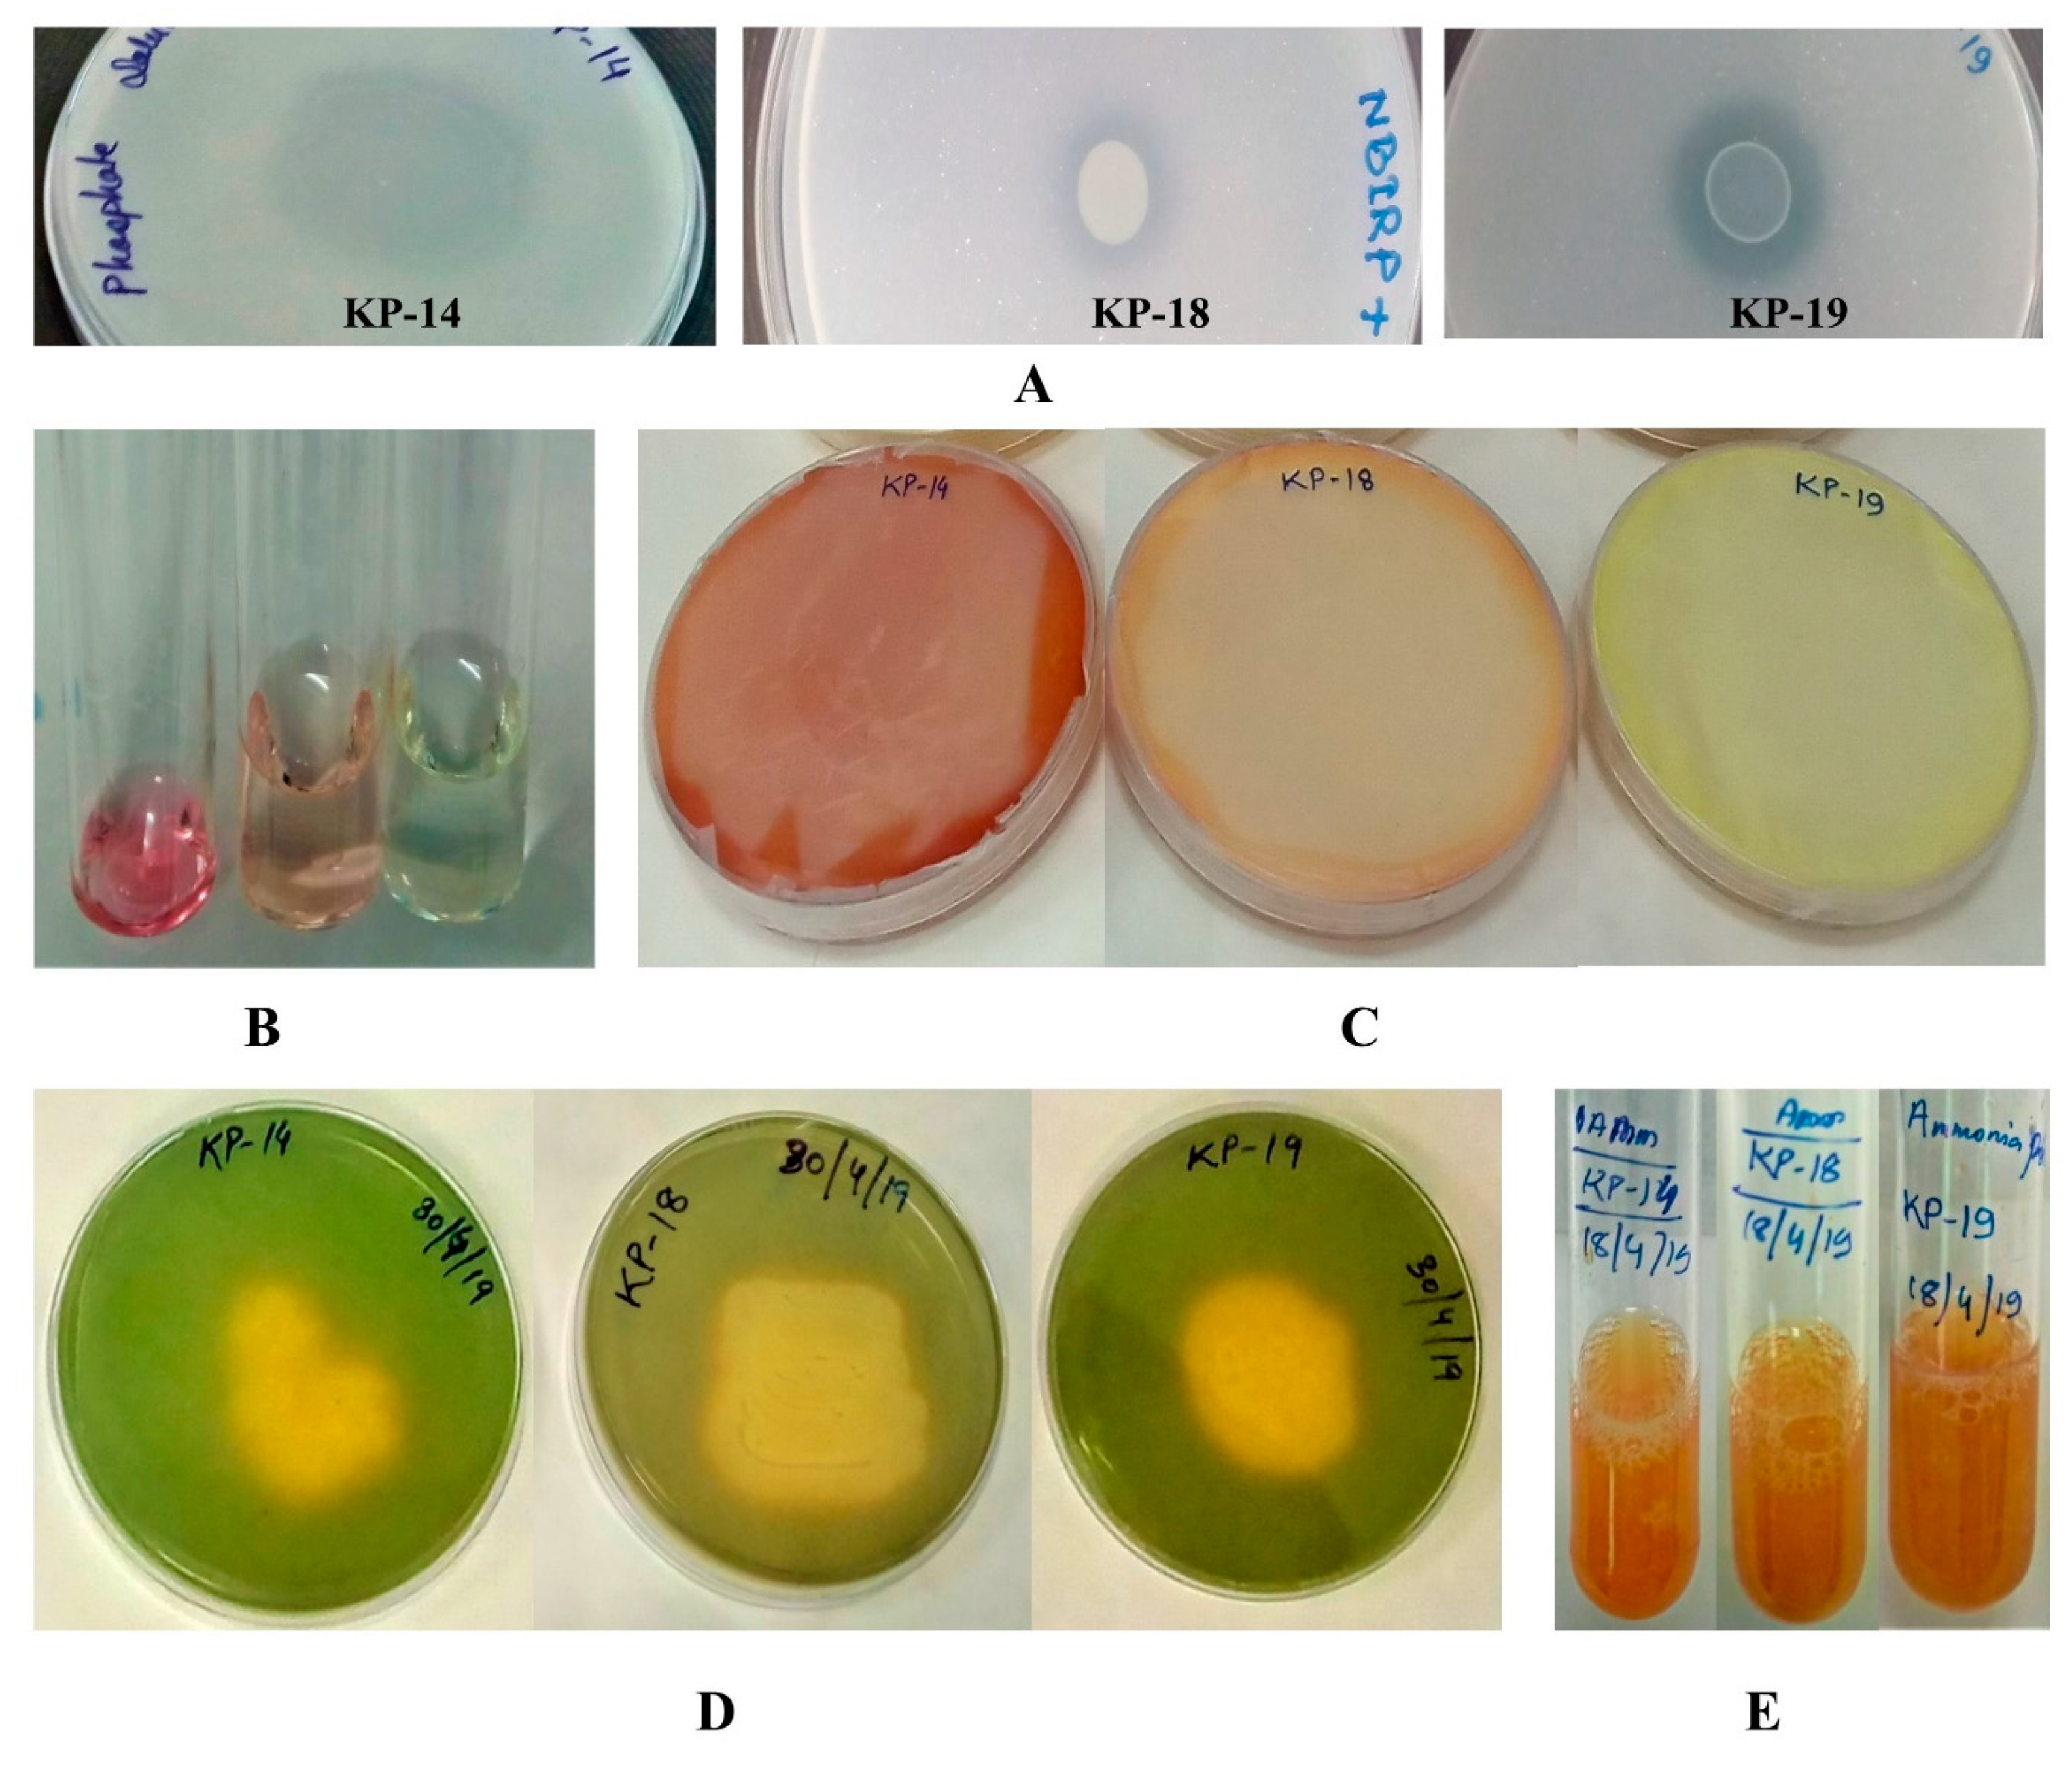
Biology 09 00305 g002

Bioprospecting of a Novel Plant Growth-Promoting Bacterium Bacillus altitudinis KP-14 for Enhancing Miscanthus × giganteus Growth in Metals Contaminated Soil
Simple Summary
Abstract
1. Introduction
2. Materials and Methods
2.1. Soil Sampling: Agrochemical and Elemental Characterization
2.2. Isolation and Identification of Plant Growth-Promoting Bacteria
16S rDNA Sequencing and Phylogenetic Analysis
2.3. Screening of Isolated Bacterial Strains for Abiotic Stress Tolerance Ability
2.3.1. Salt Tolerance
2.3.2. Temperature Tolerance
2.3.3. pH Tolerance
2.3.4. Heavy Metal Tolerance
2.4. In Vitro Assessment of Plant Growth-Promoting (PGP) Attributes
2.4.1. Inorganic Phosphate Solubilization
2.4.2. IAA Production
2.4.3. Siderophore Production
2.4.4. Hydrogen Cyanide (HCN) Production
2.4.5. ACC (1-Aminocyclopropane-1-Carboxylate) Deaminase Activity
2.4.6. Ammonia Production
2.5. In Vitro Antagonistic Bioassays against Plant Pathogenic Fungi
2.6. Seed Germination Assay
2.7. Mxg Growth in Metal-Contaminated Soil
2.8. Statistical Analysis
3. Results
3.1. Soil Agrochemical and Elemental Analyses
3.2. Identification and Biochemical Characterization of Different Isolates
3.3. Abiotic Stress Tolerance of Different Isolates
3.4. Plant Growth-Promoting Characteristics of the Selected Isolates
3.4.1. Phosphate Solubilization
3.4.2. IAA Production
3.4.3. HCN Production
3.4.4. Siderophore Production
3.4.5. Ammonia and ACC Deaminase Production
3.4.6. In Vitro Antagonistic Bioassays against Plant Pathogenic Fungi
3.4.7. Effect of B. altitudinis KP-14 on Germination of Brassica alba Seeds
3.5. In Vivo Mxg Growth Promotion by B. altitudinis KP-14
4. Discussion
5. Conclusions
Supplementary Materials
Author Contributions
Funding
Acknowledgments
Conflicts of Interest
References
- Ramakrishna, W.; Rathore, P.; Kumari, R.; Yadav, R. Brown gold of marginal soil: Plant growth promoting bacteria to overcome plant abiotic stress for agriculture, biofuels and carbon sequestration. Sci. Total Environ. 2020, 711, 135062. [Google Scholar] [CrossRef] [PubMed]
- Sharov, P.; Dowling, R.; Gogishvili, M.; Jones, B.; Caravanos, J.; McCartor, A.; Kashdan, Z.; Fuller, R. The prevalence of toxic hotspots in former Soviet countries. Environ. Pollut. 2016, 211, 346–353. [Google Scholar] [CrossRef]
- MAGIC Project Database, Marginal Land for Growing Industrial Crops (MAGIC) Project Database on MAGIC Decision Support System for Marginal Lands and Industrial Crops. 2018. Available online: http://iiasa-patial.maps.arcgis.com/apps/webappviewer/index.html?id=a813940c9ac14c298238c1742dd9dd3c (accessed on 22 December 2019).
- Pidlisnyuk, V.; Stefanovska, T.; Lewis, E.E.; Erickson, L.E.; Davis, L.C. Miscanthus as a Productive Biofuel Crop for Phytoremediation. Crit. Rev. Plant Sci. 2014, 33, 1–19. [Google Scholar] [CrossRef]
- Babu, A.G.; Shea, P.J.; Sudhakar, D.; Jung, I.-B.; Oh, B.-T. Potential use of Pseudomonas koreensis AGB-1 in association with Miscanthus sinensis to remediate heavy metal(loid)-contaminated mining site soil. J. Environ. Manag. 2015, 151, 160–166. [Google Scholar] [CrossRef] [PubMed]
- Tsao, D.T. Overview of phytotechnologies. In Phytoremediation: Advances in Biochemical Engineering/Biotechnology; Tsao, D.T., Ed.; Springer: Berlin/Heidelberg, Germany, 2003; pp. 1–50. [Google Scholar]
- Lewandowski, I.; Clifton-Brown, J.; Kiesel, A.; Hastings, A.; Iqbal, Y. Miscanthus. In Perennial Grasses for Bioenergy and Bioproducts; Alexopoulou, E., Ed.; Academic Press: London, UK, 2018; pp. 35–60. [Google Scholar]
- Pidlisnyuk, V.; Erickson, L.; Stefanovska, T.; Popelka, J.; Hettiarachchi, G.; Davis, L.; Trögl, J. Potential phytomanagement of military polluted sites and biomass production using biofuel crop Miscanthus × giganteus. Environ. Pollut. 2019, 249, 330–337. [Google Scholar] [CrossRef]
- Alasmary, Z. Laboratory-to Field-Scale Investigations to Evaluate Phosphate Amendments and Miscanthus for Phytostabilization of Lead-Contaminated Military Sites. Ph.D. Thesis, Kansas State University, Manhattan, KS, USA, 2020; 297p. Available online: https://hdl.handle.net/2097/40676 (accessed on 26 August 2020).
- Dražić, G.; Milovanović, J.; Stefanović, S.; Petrić, I. Potential of Miscanthus × giganteus for heavy metals removing from Industrial desposol. Acta Reg. Environ. 2017, 14, 56–58. [Google Scholar]
- Kharytonov, M.; Pidlisnyuk, V.; Stefanovska, T.; Babenko, M.; Martynova, N.; Rula, I. The estimation of Miscanthus × giganteus adaptive potential for cultivation on the mining and post-mining lands in Ukraine. Environ. Sci. Pollut. Res. 2019, 26, 2974–2986. [Google Scholar] [CrossRef]
- Nurzhanova, A.; Pidlisnyuk, V.; Abit, K.; Nurzhanov, C.; Kenessov, B.; Stefanovska, T.; Erickson, L. Comparative assessment of using Miscanthus × giganteus for remediation of soils contaminated by heavy metals: A case of military and mining sites. Environ. Sci. Pollut. Res. Int. 2019, 26, 13320–13333. [Google Scholar] [CrossRef]
- Tangahu, B.V.; Sheikh Abdullah, S.R.; Basri, H.; Idris, M.; Anuar, N.; Mukhlisin, M. A review on heavy metals (As, Pb, and Hg) uptake by plants through phytoremediation. Int. J. Chem. Eng. 2011, 2011, 939161. [Google Scholar] [CrossRef]
- Hu, Y.; Schäfer, G.; Duplay, J.; Kuhn, N.J. Bioenergy crop induced changes in soil properties: A case study on Miscanthus fields in the Upper Rhine Region. PLoS ONE 2018, 13, e0200901. [Google Scholar] [CrossRef]
- Antonkiewicz, J.; Kołodziej, B.; Bielińska, E.J.; Popławska, A. The possibility of using sewage sludge for energy crop cultivation exemplified by reed canary grass and giant miscanthus. Soil Sci. Annu. 2019, 70, 21–33. [Google Scholar] [CrossRef]
- Han, Y.; Zhang, L.; Gu, J.; Zhao, J.; Fu, J. Citric acid and EDTA on the growth, photosynthetic properties and heavy metal accumulation of Iris halophila Pall. cultivated in Pb mine tailings. Int. Biodeterior. Biodegrad. 2018, 128, 15–21. [Google Scholar] [CrossRef]
- Damodaran, D.; Vidya Shetty, K.; Raj Mohan, B. Effect of chelaters on bioaccumulation of Cd (II), Cu (II), Cr (VI), Pb (II) and Zn (II) in Galerina vittiformis from soil. Int. Biodeterior. Biodegrad. 2013, 85, 182–188. [Google Scholar] [CrossRef]
- Nebeská, D.; Pidlisnyuk, V.; Stefanovska, T.; Trögl, J.; Shapoval, P.; Popelka, J.; Černý, J.; Medkow, A.; Kvak, V.; Malinská, H. Impact of plant growth regulators and soil properties on Miscanthus × giganteus biomass parameters and uptake of metals in military soils. Rev. Environ. Health 2019, 34, 283–291. [Google Scholar] [CrossRef]
- Khan, W.U.; Ahmad, S.R.; Yasin, N.A.; Ali, A.; Ahmad, A. Effect of Pseudomonas fluorescens RB4 and Bacillus subtilis 189 on the phytoremediation potential of Catharanthus roseus (L.) in Cu and Pb-contaminated soils. Int. J. Phytoremediat. 2017, 19, 514–521. [Google Scholar] [CrossRef]
- Choudhary, D.K.; Varma, A.; Tuteja, N. Plant-Microbe Interaction: An Approach to Sustainable Agriculture; Springer: Berlin/Heidelberg, Germany, 2016. [Google Scholar] [CrossRef]
- Firmin, S.; Labidi, S.; Fontaine, J.; Laruelle, F.; Tisserant, B.; Nsanganwimana, F.; Pourrut, B.; Dalpé, Y.; Grandmougin, A.; Douay, F.; et al. Arbuscular mycorrhizal fungal inoculation protects Miscanthus × giganteus against trace element toxicity in a highly metal-contaminated site. Sci. Total Environ. 2015, 527–528, 91–99. [Google Scholar] [CrossRef]
- Li, D.; Voigt, T.B.; Kent, A.D. Plant and soil effects on bacterial communities associated with Miscanthus × giganteus rhizosphere and rhizomes. GCB Bioenergy 2016, 8, 183–193. [Google Scholar] [CrossRef]
- dos Santos, J.J.; Maranho, L.T. Rhizospheric microorganisms as a solution for the recovery of soils contaminated by petroleum: A review. J. Environ. Manag. 2018, 210, 104–113. [Google Scholar] [CrossRef]
- Rohrbacher, F.; St-Arnaud, M. Root exudation: The ecological driver of hydrocarbon rhizoremediation. Agronomy 2016, 6, 19. [Google Scholar] [CrossRef]
- Goswami, M.; Deka, S. Plant growth-promoting rhizobacteria—Alleviators of abiotic stresses in soil: A review. Pedosphere 2020, 30, 40–61. [Google Scholar] [CrossRef]
- Jamali, H.; Sharma, A.; Roohi; Srivastava, A. Biocontrol potential of Bacillus subtilis RH5 against sheath blight of rice caused by Rhizoctonia Solani. J. Basic Microbiol. 2019, 268–280. [Google Scholar] [CrossRef] [PubMed]
- Goswami, D.; Thakker, J.N.; Dhandhukia, P.C. Portraying mechanics of plant growth promoting rhizobacteria (PGPR): A review. Cogent Food Agric. 2016, 2. [Google Scholar] [CrossRef]
- Kasim, W.A.; Gaafar, R.M.; Abou-Ali, R.M.; Omar, M.N.; Hewait, H.M. Effect of biofilm forming plant growth promoting rhizobacteria on salinity tolerance in barley. Ann. Agric. Sci. 2016, 61, 217–227. [Google Scholar] [CrossRef]
- Albdaiwi, R.N.; Khyami-Horani, H.; Ayad, J.Y.; Alananbeh, K.M.; Al-Sayaydeh, R. Isolation and characterization of halotolerant plant growth promoting rhizobacteria from durum wheat (Triticum turgidum subsp. durum) cultivated in saline areas of the dead sea region. Front. Microbiol. 2019, 10. [Google Scholar] [CrossRef] [PubMed]
- Kumar, S.; Chauhan, P.S.; Agrawal, L.; Raj, R.; Srivastava, A.; Gupta, S.; Mishra, S.K.; Yadav, S.; Singh, P.C.; Raj, S.K. Paenibacillus lentimorbus inoculation enhances tobacco growth and extenuates the virulence of Cucumber mosaic virus. PLoS ONE 2016, 11, e0149980. [Google Scholar] [CrossRef]
- Diyansah, B.; Aini, L.Q.; Hadiastono, T. The effect of PGPR (plant growth promoting rhizobacteria) Pseudomonas fluorescens and Bacillus subtilis on leaf mustard plant (Brassica juncea L.) infected by TuMv (Turnip Mosaic Virus). J. Trop. Plant Prot. 2017, 1, 30–38. [Google Scholar]
- Ledger, T.; Poupin, M.J.; Timmermann, T.; Stuardo, M.; Gonzalez, B.; Little, C. PGPR compositions and methods for improved cultivation of tomato and potato species. U.S. Patent US10513681B2, 24 December 2019. [Google Scholar]
- Cisternas-Jamet, J.; Salvatierra-Martínez, R.; Vega-Gálvez, A.; Stoll, A.; Uribe, E.; Goñi, M.G. Biochemical composition as a function of fruit maturity stage of bell pepper (Capsicum annum) inoculated with Bacillus amyloliquefaciens. Sci. Hortic. 2020, 263, 109107. [Google Scholar] [CrossRef]
- Marastoni, L.; Pii, Y.; Maver, M.; Valentinuzzi, F.; Cesco, S.; Mimmo, T. Role of Azospirillum brasilense in triggering different Fe chelate reductase enzymes in cucumber plants subjected to both nutrient deficiency and toxicity. Plant Physiol. Biochem. 2019, 136, 118–126. [Google Scholar] [CrossRef]
- Schmidt, C.S.; Mrnka, L.; Frantík, T.; Lovecká, P.; Vosátka, M. Plant growth promotion of Miscanthus × giganteus by endophytic bacteria and fungi on non-polluted and polluted soils. World J. Microbiol. Biotechnol. 2018, 34, 48. [Google Scholar] [CrossRef]
- Begum, N.; Hu, Z.; Cai, Q.; Lou, L. Influence of PGPB inoculation on HSP70 and HMA3 gene expression in switchgrass under cadmium stress. Plants 2019, 8, 504. [Google Scholar] [CrossRef]
- USEPA. United States Standard. In Field Portable X-Ray Fluorescence Spectrometry for the Determination of Elemental Concentrations in Soil and Sediment; SW-846 Test Method 6200-2007: Washington, DC, USA, 2007. [Google Scholar]
- Gustaw, K.; Michalak, M.; Polak-Berecka, M.; Waśko, A. Isolation and characterization of a new fructophilic Lactobacillus plantarum FPL strain from honeydew. Ann. Microbiol. 2018, 68, 459–470. [Google Scholar] [CrossRef] [PubMed]
- Galkiewicz, J.P.; Kellogg, C.A. Cross-kingdom amplification using bacteria-specific primers: Complications for studies of coral microbial ecology. Appl. Environ. Microbiol. 2008, 74, 7828–7831. [Google Scholar] [CrossRef] [PubMed]
- Huerta-Cepas, J.; Serra, F.; Bork, P. ETE 3: Reconstruction, analysis, and visualization of phylogenomic data. Mol. Biol. Evol. 2016, 33, 1635–1638. [Google Scholar] [CrossRef] [PubMed]
- Bruno, L.B.; Karthik, C.; Ma, Y.; Kadirvelu, K.; Freitas, H.; Rajkumar, M. Amelioration of chromium and heat stresses in Sorghum bicolor by Cr6+ reducing-thermotolerant plant growth promoting bacteria. Chemosphere 2020, 244, 125521. [Google Scholar] [CrossRef]
- Arif, M.S.; Yasmeen, T.; Shahzad, S.M.; Riaz, M.; Rizwan, M.; Iqbal, S.; Asif, M.; Soliman, M.H.; Ali, S. Lead toxicity induced phytotoxic effects on mung bean can be relegated by lead tolerant Bacillus subtilis (PbRB3). Chemosphere 2019, 234, 70–80. [Google Scholar] [CrossRef]
- Nautiyal, C.S. An efficient microbiological growth medium for screening phosphate solubilizing microorganisms. FEMS Microbiol. Lett. 1999, 170, 265–270. [Google Scholar] [CrossRef]
- Rana, A.; Saharan, B.; Joshi, M.; Prasanna, R.; Kumar, K.; Nain, L. Identification of multi-trait PGPR isolates and evaluating their potential as inoculants for wheat. Ann. Microbiol. 2011, 61, 893–900. [Google Scholar] [CrossRef]
- Jackson, M. Soil Chemical Analysis; Prentice Hall Inc.: Englewood Cliffs, NJ, USA, 1967; pp. 331–334. [Google Scholar]
- Hartmann, A.; Singh, M.; Klingmüller, W. Isolation and characterization of Azospirillum mutants excreting high amounts of indoleacetic acid. Can. J. Microbiol. 1983, 29, 916–923. [Google Scholar] [CrossRef]
- Schwyn, B.; Neilands, J.B. Universal chemical assay for the detection and determination of siderophores. Anal. Biochem. 1987, 160, 47–56. [Google Scholar] [CrossRef]
- Bakker, A.W.; Schippers, B. Microbial cyanide production in the rhizosphere in relation to potato yield reduction and Pseudomonas SPP-mediated plant growth-stimulation. Soil Biol. Biochem. 1987, 19, 451–457. [Google Scholar] [CrossRef]
- Jacobson, C.B.; Pasternak, J.; Glick, B.R. Partial purification and characterization of 1-aminocyclopropane-1-carboxylate deaminase from the plant growth promoting rhizobacterium Pseudomonas putida GR12-2. Can. J. Microbiol. 1994, 40, 1019–1025. [Google Scholar] [CrossRef]
- Li, H.-B.; Singh, R.K.; Singh, P.; Song, Q.-Q.; Xing, Y.-X.; Yang, L.-T.; Li, Y.-R. Genetic diversity of nitrogen-fixing and plant growth promoting Pseudomonas species isolated from sugarcane rhizosphere. Front. Microbiol. 2017, 8. [Google Scholar] [CrossRef] [PubMed]
- Dye, D. The inadequacy of the usual determinative tests for the identification of Xanthomonas spp. N. Z. J. Sci. 1962, 5, 393–416. [Google Scholar]
- Shende, S.; Apte, R.; Singh, T. Influence of Azotobacter on germination of rice and cotton seeds [India]. Curr. Sci. 1977, 46, 675–676. [Google Scholar]
- Smith, J.L.; Doran, J.W. Measurement and use of pH and electrical conductivity for soil quality analysis. Methods Assess. Soil Qual. 1997, 49, 169–185. [Google Scholar]
- Couto, W. Soil pH and plant productivity. In Handbook of Agricultural Productivity; CRC Press: Boca Raton, FL, USA, 2018; pp. 71–84. [Google Scholar]
- DSTU 4729-2007. The Method for Determination of the Nitrate and Ammonium Nitrogen. National Standard of Ukraine; Quality of Soil: Kyiv, Ukraine, 2008; p. 14. [Google Scholar]
- Agegnehu, G.; Nelson, P.N.; Bird, M.I. Crop yield, plant nutrient uptake and soil physicochemical properties under organic soil amendments and nitrogen fertilization on Nitisols. Soil Till. Res. 2016, 160, 1–13. [Google Scholar] [CrossRef]
- MECR. Laying down the details of agricultural land quality protection and amending Decree No. 13/1994 Coll., Amending certain details of agricultural land resources protection. In Decree No. 153/2016; Ministry of the Environment of the Czech Republic (MECR): Prague, Czech Republic, 2016; Volume 153. [Google Scholar]
- Han, M.; Kim, Y.; Koo, B.C.; Choi, G.W. Bioethanol production by Miscanthus as a lignocellulosic biomass: Focus on high efficiency conversion to glucose and ethanol. Bioresources 2011, 6, 1939–1953. [Google Scholar]
- Cosentino, S.; Scordia, D.; Testa, G.; Monti, A.; Alexopouloy, E.; Chirtou, M. The importance of perennial grasses as a feedstock for bioenergy and bioproducts. In Perennial Grasses for Bioenergy and Bioproducts; Alexopoulou, E., Ed.; Academic Press: London, UK, 2018; pp. 1–33. [Google Scholar]
- Park, H.J.; Oh, S.W.; Wen, M.Y. Manufacture and properties of Miscanthus–wood particle composite boards. J. Wood Sci. 2012, 58, 459–464. [Google Scholar] [CrossRef]
- Villaverde, J.J.; Ligero, P.; Vega, A.D. Miscanthus × giganteus as a source of biobased products through organosolv fractionation: A mini review. Open Agric. J. 2010, 4. [Google Scholar] [CrossRef]
- Bocianowski, J.; Fabicial, E.; Joachimiak, K.; Wojech, R.; Wojciak, A. Miscanthus × giganteus as an auxiliary raw material in NSSC pulp production. Cell. Chem. Technol. 2019, 53, 1–9. [Google Scholar] [CrossRef]
- Sunar, K.; Dey, P.; Chakraborty, U.; Chakraborty, B. Biocontrol efficacy and plant growth promoting activity of Bacillus altitudinis isolated from Darjeeling hills, India. J. Basic Microbiol. 2015, 55, 91–104. [Google Scholar] [CrossRef] [PubMed]
- Mukherjee, P.; Mitra, A.; Roy, M. Halomonas rhizobacteria of Avicennia marina of Indian sundarbans promote rice growth under saline and heavy metal stresses through exopolysaccharide production. Front. Microbiol. 2019, 10, 1207. [Google Scholar] [CrossRef] [PubMed]
- Kamaruzzaman, M.A.; Abdullah, S.R.S.; Hasan, H.A.; Hassan, M.; Othman, A.R.; Idris, M. Characterisation of Pb-resistant plant growth-promoting rhizobacteria (PGPR) from Scirpus grossus. Biocatal. Agric. Biotechnol. 2020, 23, 101456. [Google Scholar] [CrossRef]
- Kumar, V.; Singh, S.; Singh, J.; Upadhyay, N. Potential of plant growth promoting traits by bacteria isolated from heavy metal contaminated soils. Bull. Environ. Contam. Toxicol. 2015, 94, 807–814. [Google Scholar] [CrossRef]
- Singh, R.P.; Jha, P.N. A halotolerant bacterium Bacillus licheniformis HSW-16 augments induced systemic tolerance to salt stress in wheat plant (Triticum aestivum). Front. Plant Sci. 2016, 7, 1890. [Google Scholar] [CrossRef]
- Orhan, F. Alleviation of salt stress by halotolerant and halophilic plant growth-promoting bacteria in wheat (Triticum aestivum). Braz. J. Microbiol. 2016, 47, 621–627. [Google Scholar] [CrossRef]
- McBride, M.B.; Kelch, S.E.; Schmidt, M.P.; Sherpa, S.; Martinez, C.E.; Aristilde, L. Oxalate-enhanced solubility of lead (Pb) in the presence of phosphate: PH control on mineral precipitation. Environ. Sci. Process. Impacts 2019, 21, 738–747. [Google Scholar] [CrossRef]
- Kour, D.; Rana, K.L.; Sheikh, I.; Kumar, V.; Yadav, A.N.; Dhaliwal, H.S.; Saxena, A.K. Alleviation of drought stress and plant growth promotion by Pseudomonas libanensis EU-LWNA-33, a drought-adaptive phosphorus-solubilizing bacterium. Proc. Natl. Acad. Sci. India Sec. B Biol. Sci. 2019. [Google Scholar] [CrossRef]
- Chennappa, G.; Udaykumar, N.; Vidya, M.; Nagaraja, H.; Amaresh, Y.S.; Sreenivasa, M.Y. Chapter 19—Azotobacter—A natural resource for bioremediation of toxic pesticides in soil ecosystems. In New and Future Developments in Microbial Biotechnology and Bioengineering; Singh, J.S., Singh, D.P., Eds.; Elsevier: Amsterdam, The Netherlands, 2019; pp. 267–279. [Google Scholar] [CrossRef]
- Glick, B.R.; Jacobson, C.B.; Schwarze, M.M.; Pasternak, J. 1-Aminocyclopropane-1-carboxylic acid deaminase mutants of the plant growth promoting rhizobacterium Pseudomonas putida GR12-2 do not stimulate canola root elongation. Can. J. Microbiol. 1994, 40, 911–915. [Google Scholar] [CrossRef]
- Zhang, S.; Gan, Y.; Xu, B. Mechanisms of the IAA and ACC-deaminase producing strain of Trichoderma longibrachiatum T6 in enhancing wheat seedling tolerance to NaCl stress. BMC Plant Biol. 2019, 19, 22. [Google Scholar] [CrossRef]
- Tahir, M.; Ahmad, I.; Shahid, M.; Shah, G.M.; Farooq, A.B.U.; Akram, M.; Tabassum, S.A.; Naeem, M.A.; Khalid, U.; Ahmad, S.; et al. Regulation of antioxidant production, ion uptake and productivity in potato (Solanum tuberosum L.) plant inoculated with growth promoting salt tolerant Bacillus strains. Ecotox. Environ. Saf. 2019, 178, 33–42. [Google Scholar] [CrossRef] [PubMed]
- Shivaji, S.; Chaturvedi, P.; Suresh, K.; Reddy, G.S.N.; Dutt, C.B.S.; Wainwright, M.; Narlikar, J.V.; Bhargava, P.M. Bacillus aerius sp. nov., Bacillus aerophilus sp. nov., Bacillus stratosphericus sp. nov. and Bacillus altitudinis sp. nov., isolated from cryogenic tubes used for collecting air samples from high altitudes. Int. J. Syst. Evol. Microbiol. 2006, 56, 1465–1473. [Google Scholar] [CrossRef] [PubMed]
- Reina-Bueno, M.; Argandoña, M.; Nieto, J.J.; Hidalgo-García, A.; Iglesias-Guerra, F.; Delgado, M.J.; Vargas, C. Role of trehalose in heat and desiccation tolerance in the soil bacterium Rhizobium etli. BMC Microbiol. 2012, 12, 207. [Google Scholar] [CrossRef] [PubMed]
- Baker, A.J.M.; McGrath, S.P.; Reeve, R.D.; Smith, J.A.C. Metal hyperaccumulator plants: A review of the ecology and physiology of a biological resource for phytoremediation of metal-polluted soils. In Phytoremediation of Contaminated Soil and Water; Terry, N., Banuelos, G.S., Eds.; Lewis Publishers, CRC Press: Boca-Raton, FL, USA, 2000; pp. 85–107. [Google Scholar]
- Khezri, M.; Jouzani, G.S.; Ahmadzadeh, M. Fusarium culmorum affects expression of biofilm formation key genes in Bacillus subtilis. Braz. J. Microbiol. 2016, 47, 47–54. [Google Scholar] [CrossRef]
- Fira, D.; Dimkić, I.; Berić, T.; Lozo, J.; Stanković, S. Biological control of plant pathogens by Bacillus species. J. Biotechnol. 2018, 285, 44–55. [Google Scholar] [CrossRef]
- Toral, L.; Rodríguez, M.; Béjar, V.; Sampedro, I. Antifungal activity of lipopeptides from Bacillus XT1 CECT 8661 against Botrytis cinerea. Front. Microbiol. 2018, 9. [Google Scholar] [CrossRef]
- Woyessa, D.; Assefa, F. Effects of plant growth promoting rhizobacteria on growth and yield of tef (Eragrostis tef Zucc. Trotter) under greenhouse condition. Res. J. Microbiol. 2011, 6, 343–355. [Google Scholar] [CrossRef]
- Sorty, A.M.; Meena, K.K.; Choudhary, K.; Bitla, U.M.; Minhas, P.S.; Krishnani, K.K. Effect of plant growth promoting bacteria associated with halophytic weed (Psoralea corylifolia L.) on germination and seedling growth of wheat under saline conditions. Appl. Biochem. Biotechnol. 2016, 180, 872–882. [Google Scholar] [CrossRef]
- Kang, S.-M.; Khan, A.L.; Waqas, M.; Asaf, S.; Lee, K.-E.; Park, Y.-G.; Kim, A.-Y.; Khan, M.A.; You, Y.-H.; Lee, I.-J. Integrated phytohormone production by the plant growth-promoting rhizobacterium Bacillus tequilensis SSB07 induced thermotolerance in soybean. J. Plant Interact. 2019, 14, 416–423. [Google Scholar] [CrossRef]
- Mukhtar, S.; Zareen, M.; Khaliq, Z.; Mehnaz, S.; Malik, K.A. Phylogenetic analysis of halophyte-associated rhizobacteria and effect of halotolerant and halophilic phosphate-solubilizing biofertilizers on maize growth under salinity stress conditions. J. Appl. Microbiol. 2020, 128, 556–573. [Google Scholar] [CrossRef]
- Fei, H.; Crouse, M.; Papadopoulos, Y.A.; Vessey, J.K. Improving biomass yield of giant Miscanthus by application of beneficial soil microbes and a plant biostimulant. Can. J. Plant Sci. 2019, 100, 29–39. [Google Scholar] [CrossRef]

root length,
shoot length, and
germination index (%)).
root length,
shoot length, and
germination index (%)).
Uninoculated control;
Inoculated treatment). Displayed data is the mean ± SE value of four replicates of each treatment. Asterisks denote significant differences between control and strain KP-14 experiment with four replicates (ANOVA, * p < 0.001, ** p < 0.0001).
Uninoculated control;
Inoculated treatment). Displayed data is the mean ± SE value of four replicates of each treatment. Asterisks denote significant differences between control and strain KP-14 experiment with four replicates (ANOVA, * p < 0.001, ** p < 0.0001).
| Isolates | Gram Reaction | Colony Morphology | Nearest Neighbor/Accession Number | % Similarity with Nearest Neighbor | No. of Nucleotides | Assigned NCBI Accession Number |
|---|---|---|---|---|---|---|
| KP-4 | Gram-positive | Circular, convex, slimy, white, entire margin | Bacillus pumilus/KJ526890 | 98.4 | 1463 | MN947642 |
| KP-5 | Gram-positive | Circular, elevation raised, dry, white Irregular margin | Bacillus pumilus/KC692175 | 98.4 | 1472 | MN947643 |
| KP-9 | Gram-positive | Circular, convex, glossy, transparent, entire margin | Bacillus stratosphericus/KJ572539 | 98.5 | 1466 | MN947644 |
| KP-13 | Gram-negative | Circular, elevation raised, yellow tint, entire margin | Stenotrophomonas maltophilia/DQ113454 | 98.0 | 1440 | MN947645 |
| KP-14 | Gram-positive | Circular, convex, slimy, white, entire margin | Bacillus altitudinis/MF511821 | 100.0 | 1550 | MN966966 |
| KP-16 | Gram-negative | Circular, convex, white, entire margin | Pseudomonas fluorescens/DQ178227 | 99.9 | 996 | MN966967 |
| KP-17 | Gram-negative | Circular, convex, yellowish white, entire margin | Pseudomonas fluorescens/KT695813 | 98.4 | 1376 | MN947646 |
| KP-18 | Gram-positive | Circular, convex, glossy, light yellow, entire margin | Bacillus sp./MK571667 | 99.5 | 1035 | MN947647 |
| KP-19 | Gram-negative | Circular, convex, light yellow, entire margin | Achromobacter sp./MN515103 | 99.1 | 1090 | MN947648 |
| Carbon Source | Bacterial Isolate | ||||||||
|---|---|---|---|---|---|---|---|---|---|
| KP-4 | KP-5 | KP-9 | KP-13 | KP-14 | KP-16 | KP-17 | KP-18 | KP-19 | |
| Lactose | + | − | − | − | + | − | − | − | − |
| Xylose | − | − | − | + | + | + | + | − | − |
| Maltose | − | − | − | − | + | − | − | − | − |
| Fructose | + | + | + | − | − | − | − | − | − |
| Dextrose | + | + | + | + | + | + | + | + | − |
| Galactose | − | − | + | + | + | − | + | − | − |
| Raffinose | − | − | − | − | − | − | − | − | − |
| Trehalose | + | + | + | − | + | − | − | − | − |
| Melibiose | − | − | − | − | + | + | + | + | − |
| Sucrose | + | + | + | − | − | + | − | − | − |
| L-Arabinose | + | + | + | − | + | + | + | − | + |
| Mannose | + | + | + | + | + | + | + | + | + |
| Inulin | + | − | + | − | − | − | − | − | − |
| Sodium gluconate | − | + | − | − | − | − | − | − | − |
| Glycerol | − | − | − | − | − | − | − | − | − |
| Salicin | + | + | + | − | − | − | − | − | + |
| Dulcitol | − | − | − | − | − | − | − | − | − |
| Inositol | − | − | − | − | − | − | − | − | − |
| Sorbitol | − | − | − | − | − | − | − | − | − |
| Mannitol | + | + | + | − | − | − | − | − | − |
| Adonitol | − | − | − | − | − | − | − | − | − |
| Arabitol | − | − | − | − | − | − | − | − | − |
| Erythritol | − | − | − | − | − | − | − | − | − |
| α-Methyl-D-glucoside | − | − | − | − | − | − | − | − | − |
| Rhamnose | − | − | − | − | + | + | + | − | − |
| Cellobiose | + | + | + | − | + | − | − | − | − |
| Melezitose | − | − | − | − | − | − | − | − | − |
| α-Methyl-D-mannoside | − | − | − | + | − | − | − | − | − |
| Xylitol | − | − | − | − | − | − | − | − | − |
| ONPG | − | − | − | − | − | − | − | − | − |
| Esculin hydrolysis | + | + | + | + | + | + | − | + | + |
| D-Arabinose | − | − | − | − | + | − | + | − | − |
| Citrate | + | + | + | + | + | + | + | + | + |
| Malonate | + | + | + | + | + | + | + | + | + |
| Sorbose | − | − | − | − | − | − | − | − | − |
| Abiotic Stresses | Isolated Strains | ||||||||
|---|---|---|---|---|---|---|---|---|---|
| KP-4 | KP-5 | KP-9 | KP-13 | KP-14 | KP-16 | KP-17 | KP-18 | KP-19 | |
| Temperature (°C) | |||||||||
| 4 | − | − | − | +++ | +++ | ++ | +++ | +++ | − |
| 10 | − | − | − | +++ | +++ | ++ | +++ | +++ | − |
| 16 | − | − | − | +++ | +++ | +++ | +++ | +++ | − |
| 22 | +++ | +++ | +++ | +++ | +++ | +++ | +++ | +++ | +++ |
| 28 | +++ | +++ | +++ | +++ | +++ | +++ | +++ | +++ | +++ |
| 37 | +++ | +++ | +++ | − | +++ | − | − | +++ | +++ |
| 45 | +++ | +++ | +++ | − | +++ | − | − | ++ | ++ |
| 50 | ++ | − | − | − | ++ | − | − | ++ | ++ |
| Salinity (%) | |||||||||
| 0 | +++ | +++ | +++ | +++ | +++ | +++ | +++ | +++ | +++ |
| 2 | +++ | +++ | +++ | +++ | +++ | +++ | +++ | +++ | +++ |
| 4 | +++ | +++ | +++ | +++ | +++ | ++ | ++ | +++ | +++ |
| 6 | ++ | +++ | +++ | − | +++ | − | − | +++ | +++ |
| 8 | ++ | +++ | +++ | − | +++ | − | − | +++ | +++ |
| 10 | − | ++ | ++ | − | +++ | − | − | +++ | +++ |
| 12 | − | − | − | − | +++ | − | − | ++ | ++ |
| 15 | − | − | − | − | ++ | − | − | − | ++ |
| pH | |||||||||
| 4 | +++ | +++ | +++ | − | − | − | − | +++ | − |
| 5 | +++ | +++ | +++ | +++ | +++ | +++ | +++ | +++ | +++ |
| 6 | +++ | +++ | +++ | +++ | +++ | +++ | +++ | +++ | +++ |
| 7 | +++ | +++ | +++ | +++ | +++ | +++ | +++ | +++ | +++ |
| 8 | +++ | +++ | +++ | +++ | +++ | +++ | +++ | +++ | +++ |
| Pb toxicity (ppm) | |||||||||
| 100 | +++ | +++ | +++ | +++ | +++ | +++ | +++ | +++ | +++ |
| 300 | +++ | +++ | +++ | +++ | +++ | +++ | +++ | +++ | +++ |
| 500 | +++ | +++ | +++ | +++ | +++ | +++ | +++ | +++ | +++ |
| 700 | +++ | +++ | +++ | +++ | +++ | +++ | +++ | +++ | +++ |
| 1000 | − | − | − | − | +++ | − | − | +++ | +++ |
| 1200 | − | − | − | − | + | − | − | + | + |
| 1500 | − | − | − | − | − | − | − | − | − |
| Isolate | P Solubilization (µg/mL) | Indole Acetic Acid (IAA) (µg/mL) | 1-Aminocyclopropane-1-Carboxylate) (ACC) Deaminase Activity | Ammonia | Siderophore | Hydrogen Cyanide (HCN) | Antifungal Activity | |
|---|---|---|---|---|---|---|---|---|
| Fusarium culmorum (CCF-1745) | Botrytis cinerea (CCF-2361) | |||||||
| KP-14 | 130.0 ± 3.2 | 27.8 ± 0.8 | + | + | + | + | + | + |
| KP-18 | 14.5 ± 2.9 | 10.5 ± 0.2 | − | + | + | + | + | − |
| KP-19 | 32.8 ± 1.2 | 1.1 ± 0.7 | − | + | + | − | − | − |
| Organism | Salt Tolerance (%) | Thermo Tolerance (°C) | P Solubilization | IAA | ACC | Ammonia | Siderophore | HCN | Reference |
|---|---|---|---|---|---|---|---|---|---|
| B. subtilis AURB65 | 5 | 60 | + | * | * | * | * | + | [81] |
| B. altitudinis BRHS/S-73 | * | * | + | + | * | * | + | + | [63] |
| Bacillus sp. EL1 | 2 | * | − | + | − | * | * | * | [68] |
| Bacillus sp. NIASMIII | 12 | * | − | + | − | * | + | * | [82] |
| B. licheniformis HSW-16 | 11 | * | + | + | + | * | − | * | [67] |
| Bacillus sp. SR-2-1/1 | 10 | * | + | + | + | * | * | * | [74] |
| B. subtilis GSW-E-6 | 2 | * | − | + | + | * | + | * | [29] |
| B. tequilensis SSB07 | * | 35 | * | + | * | * | * | * | [83] |
| B. subtilis RH5 | 10 | 45 | + | + | * | + | + | + | [26] |
| B. pumilus HL3RS14 | 20 | * | + | + | * | * | − | − | [84] |
| B. cereus TCR17 | * | 50 | + | + | * | * | + | * | [41] |
| B. proteolyticus 4D | * | * | + | + | − | + | − | * | [65] |
| B. velezensis 9I | * | * | + | + | − | + | + | * | [65] |
| B. altitudinis KP-14 | 15 | 50 | + | + | + | + | + | + | This study |
© 2020 by the authors. Licensee MDPI, Basel, Switzerland. This article is an open access article distributed under the terms and conditions of the Creative Commons Attribution (CC BY) license (http://creativecommons.org/licenses/by/4.0/).
Share and Cite
Pranaw, K.; Pidlisnyuk, V.; Trögl, J.; Malinská, H. Bioprospecting of a Novel Plant Growth-Promoting Bacterium Bacillus altitudinis KP-14 for Enhancing Miscanthus × giganteus Growth in Metals Contaminated Soil. Biology 2020, 9, 305. https://doi.org/10.3390/biology9090305
Pranaw K, Pidlisnyuk V, Trögl J, Malinská H. Bioprospecting of a Novel Plant Growth-Promoting Bacterium Bacillus altitudinis KP-14 for Enhancing Miscanthus × giganteus Growth in Metals Contaminated Soil. Biology. 2020; 9(9):305. https://doi.org/10.3390/biology9090305
Chicago/Turabian StylePranaw, Kumar, Valentina Pidlisnyuk, Josef Trögl, and Hana Malinská. 2020. "Bioprospecting of a Novel Plant Growth-Promoting Bacterium Bacillus altitudinis KP-14 for Enhancing Miscanthus × giganteus Growth in Metals Contaminated Soil" Biology 9, no. 9: 305. https://doi.org/10.3390/biology9090305
APA StylePranaw, K., Pidlisnyuk, V., Trögl, J., & Malinská, H. (2020). Bioprospecting of a Novel Plant Growth-Promoting Bacterium Bacillus altitudinis KP-14 for Enhancing Miscanthus × giganteus Growth in Metals Contaminated Soil. Biology, 9(9), 305. https://doi.org/10.3390/biology9090305

